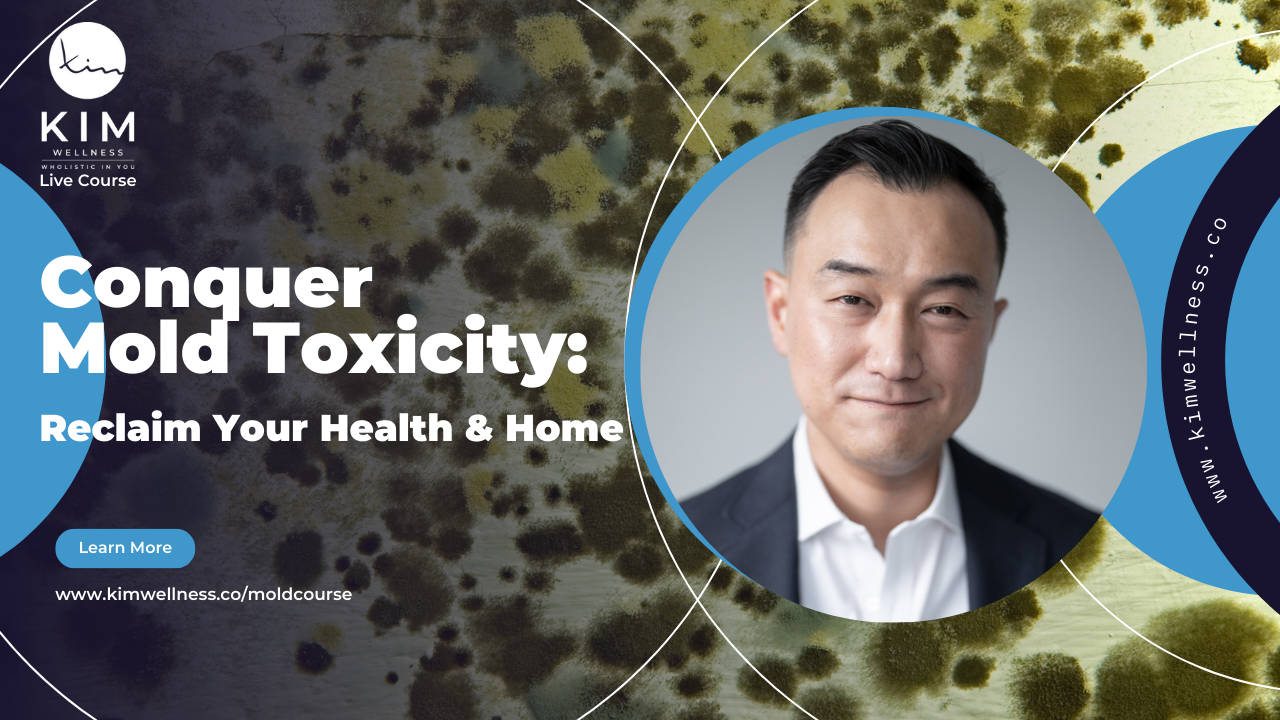

Welcome!!
Listeners of the HOMeHOPe w/ Dr. Scott Scherr, MD
Don't let mold control your health journey.
Transform your life with evidence-based solutions
Do you suffer from unexplained fatigue, brain fog, headaches, or digestive issues? Mold toxicity could be the hidden culprit.
Mold is a common environmental toxin that can have a devastating impact on our health. Our "Conquer Mold Toxicity" course can help you:
-
Identify and eliminate mold sources
-
Detoxify your body from mold toxins
-
Restore your health and vitality
USE CODE: HOMEHOPE for $250
🔋 REBOOT YOUR CELLULAR HEALTH
Â
Your cells are constantly bombarded by:
• Environmental toxins
• Processed foods
• EMF exposure
• Oxidative stress
The solution? Feed your cells what they're truly hungry for.
Transform your cellular health with BodyBio's premium phospholipid supplements:
BodyBio PC (Phosphatidylcholine)
-
Repairs cell membranes
-
Supports brain function
-
Enhances energy production
BodyBio Balance Oil
-
Optimal 4:1 ratio of Omega-6 to Omega-3
-
Supports cellular communication
-
Reduces inflammation
Â
Don't let compromised cell membranes hold you back from optimal health. Start your cellular reboot today!
Â
Get 15% OFF with CODE: DRKIM
Shop Body Bio